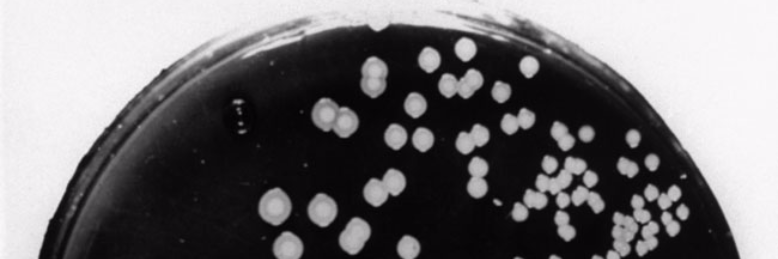
Cover image for post Petri Dish, by themanmoth

You are the Hero of Your Story
But we became the two protagonists of the same adventure:
co-authoring our book,
we scattered our chapters across the world in our most intimate moments
like pink petals, divots of love in a bland landscape.
Our bodies and lifetimes are hopelessly entangled--
but I wouldn't want it any other way.
space
space is an encompassing term;
it wraps around,
around the pearl made of crying little clams,
around the pearls tossed before swine, around the moon, who can be
a little
lonely
watching the children so frightened of the dark that they never look to see the glow.
space is the twenty-cent cheap necklace that immigrant mothers wear
but at one point or another,
when the limit no longer exists, back bent to infinity,
the string on the necklace will snap
and the pearls (the space) will scatter across the bleached tiles,
only to blend in with the color of muteness.
negative space is not a recognized concept;
we see positive space,
people, places, things taking up volume
all made of matter, neither created, nor destroyed,
just transferred from form to form, roaming to find a host called home .
(but does that even matter?)
we do not see the island in the curve of arm on hip
or the gaps between fingers missing significant others.
we do not see that the sunset goes up forty-four times,
tracing not the little prince, single inhabitant of his planet,
but the emptiness around him.
space is a filled emptiness.
it is.
a body gives her all, transfers all her matter into
people, places, things cranking up the volume
black holes consuming all that ever could’ve mattered at this zero point
so that sound swallows the space whole, so that a body loses itself,
becomes a no
body
in the blur of noise that come from the mouths
of a people who muffle their screams with scarves.
the no body trembles
its zipper mouth swinging in the gusts of the sandstorm made out of clam tears.
trust me when I say--
i am physically incapable of saying things
that take up space the way words are supposed to,
that i’ll point out shapes and colors so you can look between the lines,
see the absence of things that so clearly defines what mattered, like the:
silhouette of an alone moon
seeds sewn out of dreams under pig hooves
clams tucked into the sand of tourist beaches
the meaning to this poem
7 Applications of the Word “Why”
1. Appears in the hit song "I Want It That Way" by the Backstreet Boys as the boy band serenades you with mournful eyes and 1990s haircuts.
2. "Why?" chirps the five-year-old child for the umpteenth time and you have to restrain yourself from bashing your head against a brick wall because you can't take any more questions.
3. Reoccurs in conversations where the protagonist screams a heart-wrenching "WHY?!" at their best friend who's betrayed them to go to the dark side.
4. Spoken on a regular basis by angsty teen philosophers, brow furrowing as they ask themselves rhetorical questions and engage in existential crises (See also: Hamlet)
5. "Remember to ask yourself 'Who? What? Where? When? Why?'" instructs the fourth-grade teacher and the class of elementary-schoolers heaves yet another groan.
6. The one question you ask yourself, your voice of reason attempting to stop you before you do something like ridiculous and irrational like...
7. ....wasting two minutes of your life reading this list. Now why on Earth did you do that?
Petri Dish
accidents walking into verloving doors
colliding with too-good-to-be-trues and ain't-you-just-a-fools
what a mess! cultured stars in the Hefty garbage-bag nights
with an unbreakable pinky-swear to care take of crime
all and for once.
laugh with me:
coin-rattling incidences taste like moons with Hershey Kisses for craters and
the slight of hand leads to fortuitous happy-stances.
Rest in Pieces
Last Thursday night, the landlady kicked her out of her own body because she couldn't afford the price of living (the rent was too damn high) but everything was all right:
she had fought the good fight, fallen in love with love, and kicked the bucket across the space-time continuum.
Talking to the Moon
author's note: I wrote "Talking to the Moon" after receiving a call from a close friend who told me they had just overdosed on medication in an attempt to commit suicide. After a group of my other friends and I called a suicide hotline, the friend who had overdosed was placed in a hospital and thankfully survived the ordeal...but the experience left such an enormous impact on me in that moment that I had to write everything out. Thank you in advance for reading.
__________
I’ve been sitting here for days now, just me alone in a room with nothing more than a chair, a desk, and a phone. The chair’s only the second-most important, I suppose---it’s supported my body as I’ve waited for the most important item, namely the phone. Or rather, it’s the phone call that reigns over the situation. After waiting a while, it’s gotten so that I know only that the moment the phone rings and I pick up, everything will fade into white noise, except the phone, the wire plugged into some outlet that doesn’t exist, and the silhouette of my hand gripping the phone. Perhaps, my mouth will be there too, a pair of lips floating in mid-air that exists only to speak to a disembodied being on the other side of the receiver.
Your body is somewhere out there and I’d like to think your soul is inside that body. You always said that your soul was cramped, being stuffed inside like that. You said it’d be nice if you could let go one day. But I have always wanted to tell you that I would rather your soul be tied to a body than to have it drift off where it cannot be reached any longer.
I’m sorry. I hope you forgive me. I’m sorry enough to tell you this but not sorry enough so that when you first call me, I’ll tell you I’m goddamn glad you exist. We don’t have to be even that close-----miles apart, even when I can’t see you with my own eyes, I want to know that you’re still alive and safe and sound. The neighbors say I’m crazy. They can see me in this room with only a chair, a desk, and a phone and they think I’m crazy for clinging onto an invisible tendril of faith.
They say you’re not here, not present anymore, that if I can’t even see you, then anything could’ve happened at this rate. Maybe you decided to shut the lights and go to sleep and planned to never wake up. Maybe a nuclear explosion happened on the other end and the one night the desk rattled a little too much to be normal because it felt only the after-effects of a tragedy that decimated you and every other living being within a hundred mile radius. Maybe you don’t have it in you to call me anymore. Anything could’ve happened at this rate.
Nothing more than a chair, a desk, a phone, and me but that “anything” takes up most of the space in the room. I was never an optimist to anything except for when it came to you. That phone cord that’s not connected to anything is actually linked somewhere to your pulse and if I close my eyes with enough force, I can convince myself that it’s your heartbeat pounding away inside my chest. It’s only when I fall asleep that the heartbeats fall aside so I tell myself that over that vast distance between us, you must’ve fallen asleep too. I wonder if you dream the dreams I dream or if you wake up, the absence of air strangling your lungs and black holes appearing in your vision as you see everything being swallowed whole by blips of panic.
I tell myself that everything’s all right. The phone’s there, molded plastic with its batteries that feels slippery in my hand, and the phone on the other side must exist too. It must be waiting for you to pick it up, to dial its buttons and to hear the start of springtime. There must be a hand that yearns to hold that phone, a pair of your floating lips, and then the rest of you because you have never disappeared from me.
Listen, the French don’t say, “I miss you.” They say, “you are missing from me” and you really are. Anything could happen in the next second, minute, hour, day---but I keep on staring at the phone because that’s all that’s left of you and you are not gone yet, not when I don’t know what’s going on on the other side and I believe in you because you’ve already made it this far, contrary to all belief. You defy the laws of this world. You’re a miracle. You know that? You’re a miracle and that’s the second thing I’m going to tell you once you call me and I pick up the phone and tell you first that I’m goddamn glad you’re here. I’ll wait however long it takes, even if you’re not there to give me a call, because you’ve made it out alive too many times to count and there is no final strike to you; there’s only that moment where the sun’s rays will strike you and you will catch alight, your radiance spilling out of you in all directions, dipping the horizon a tender silver.
I’ve been sitting here for days now, just me alone in a room with nothing more than a chair, a desk, and a phone but it’s funny since I really don’t know how many days it’s been because there’s no windows in this place. But let me tell you what---the third thing I’ll tell you as soon as you call me is that I know for sure that days have passed because I have felt each and every new beginning pass me by. I have felt the flip of calendar pages, I have felt the chariot of the sun creak as it rolled across the sky. There will be one time I’m sure that new beginning will belong to you. That’s the day you’ll call me.
In our last phone call, I asked you if you believed in guardian angels. I told you that the ones who loved you and couldn’t physically be with you would continue to watch you from another dimension. They’d be rooting for you. They’d watch you until the day you could be okay with yourself---and then they’d watch you after that because love doesn’t know how to give up. Minutes later, you hung up and I told myself that everything would be all right because there were guardian angels perched on your end, watching over you.
I’ll keep waiting. It’s a promise and to tell you the truth, I’ve written this, fully convinced that tomorrow, you’ll call me and tell me that you’re alive and that it’s a miracle you came to be and that you’re caught the next train headed for a bright future; that tomorrow, after you finish that call, I’ll see you and your body and your soul inside that body and the three of you will sit down to read what I’ve written; that tomorrow, we’ll leave behind this room with its desk and its chair and its phone and settle instead for a nice walk along the lining of a good night and all the good mornings that come afterwards.
Both the Universe and I are Glad You Exist
I'm glad that you're alive.
You're irreplaceable. Your existence is priceless. Your life is a masterpiece.
Please don't give up. Your story isn't meant to end yet. There's an important place for you in this world and a bright future waiting for you.
I believe in you. You're worth it.
Just Your Everyday Existential Crisis
Humans live vicariously. We're just vessels waiting to be filled up, always lusting after something or another, but the thing is, our emptiness is impossible to satiate. Unsatisfied, we poke our noses into each other's business, peering through the windows of the soul to squeeze every last drop of third-person thrill we can.
....Yeah. I'm talking about you. I can bet you're watching me somehow.
Look, there's no script for me. No one's feeding me lines behind-the-scenes, telling me to act or talk some way so I can provoke some sort of reaction. There's no right or wrong answer---and that's what kills me.
....I can see 'em. Timelines stretched out, from the beginning of time and back. And every damn decision I make spawns a million different parallel universes.
Say I go out to buy chocolate ice cream. Since I bought the last portion of chocolate ice cream, the shop has run out of that flavor. But then the President comes walking in, demanding for a chocolate ice cream cone. Because there's no chocolate ice cream left, the President's in a bad mood, which means they go ahead and botch a diplomatic deal with another country. That then leads to rising tensions, a world war being declared, and then the apocalypse.
....Now, if I'd just bought vanilla ice cream, everything would go differently.
Hypothetically.
...To hell with hypotheticals. There's chain reactions going off in my head every day; anxiety-inducing Big Bangs, universes exploding into existence every time I so much as take another breath.
I know. I know you're out there. You can see all the timelines too. You can see what I should've, could've, ought to have damn done. And you look down on me for not having the foresight to produce the best outcome.
Good thing you're not living out my reality---otherwise, you'd be flailing around as much as I am.
Nah. I'm just a plot device, a character foil, background noise to you. Just like how you know what's best for others until you're the one suffering the consequences.
....Fun, isn't it? Go on.
Laugh.
Sagittarius
Feeling a little lonely? Befriend the monsters underneath your bed; they make for good company.
If you're in a more adventurous mood, venture into daylight and smile at the next stranger who makes eye contact with you. Good things (namely, fateful encounters and life-changing moments) come to those who wait.